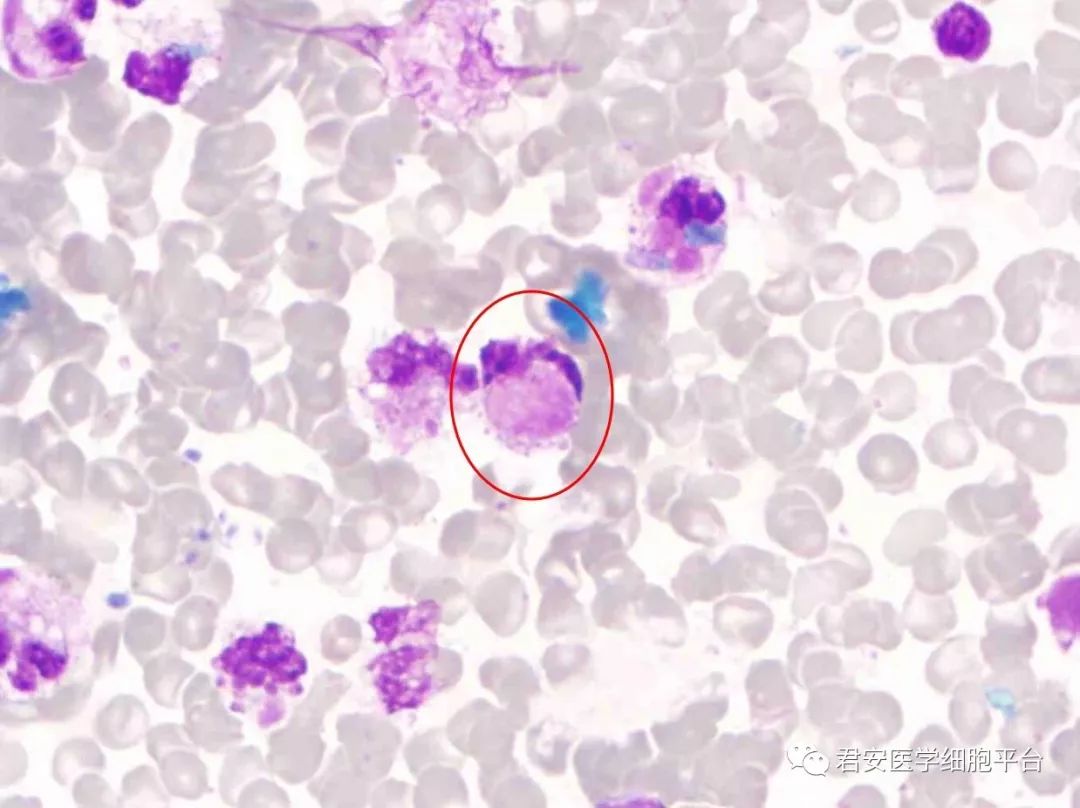
不寻常的均匀体_细胞

风湿细胞

风湿小体 枭眼细胞和毛虫细胞 7风湿性心肌炎
图片尺寸1080x810
风湿细胞
图片尺寸268x174
新认识的一种风湿病:igg4相关性疾病(下)
图片尺寸755x518
风湿性心肌炎10×40绘图要点:绘出风湿小体,风湿细胞横切面(枭眼状)和
图片尺寸1840x4000
高倍镜下观察:风湿肉芽肿的形成是由风湿细胞,风湿巨细胞,纤维素性
图片尺寸1080x1439
valvular heart disease (images)
图片尺寸500x341
风湿性心肌炎10×40绘图要点:绘出风湿小体,风湿细胞横切面(枭眼状)和
图片尺寸1840x4000
类风湿关节炎滑膜成纤维细胞
图片尺寸1065x711
病案伴有紧张性水疱的风湿性中性粒细胞皮病
图片尺寸467x705
1症状编辑 纤维素样坏死,成团的风湿细胞及伴随的淋巴细胞,浆细胞等
图片尺寸268x268
9.5 注意风湿细胞两种形态9.59.
图片尺寸2048x1536
9.0分 注意心衰细胞内的色素不要用蓝色画成纤维细胞画的太大了
图片尺寸2048x1536
不寻常的均匀体_细胞
图片尺寸1080x808
血液与风湿免疫专业讨论版 - 爱爱医医学论坛
图片尺寸516x583
治疗类风湿关节炎的首选——间充质干细胞
图片尺寸640x480
又一款类风湿关节炎新药上市干细胞疗法也可占有一席之位
图片尺寸800x480
风湿性心肌炎10×40绘图要点:绘出风湿小体,风湿细胞横切面(枭眼状)和
图片尺寸1354x797
b细胞靶向治疗风湿免疫病怎么用风免大咖云讲堂
图片尺寸420x635
1mg/l;ana抗体阳性(1:640),类风湿因子(rf),抗中性粒细胞胞浆抗体
图片尺寸1080x620
新发现科学家鉴别出诱发风湿性关节炎的两类成纤维细胞有望开发新型
图片尺寸600x336